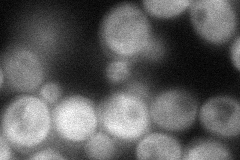
YLR369W
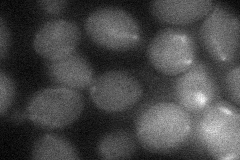
YLR369W

View description
Mitochondrial hsp70-type molecular chaperone, required for assembly of iron/sulfur clusters into proteins at a step after cluster synthesis, and for maturation of Yfh1p, which is a homolog of human frataxin implicated in Friedreich's ataxia
Localization:
Intensity:
Fold change:
Significance:
-
C’ GFP library in SD

mitochondria33.31 -
N' NOP1pr-GFP in SD
cytosol61.4506 -
N' TEF2pr-mCherry in SD

cell periphery,vacuole0 -
N' NATIVEpr-GFP in SD

missing0 -
N' TEF2pr-VC and Cyto-VN in SD
cytosol,mitochondria30.0973 -
C’ GFP library in SD+DTT

mitochondria42.51.27No -
C’ GFP library in SD+H2O2

mitochondria42.91.28No -
C’ GFP library in Starvation Media

mitochondria34.541.03No -
C’ GFP library on the background of Pup2-DaMP

mitochondria -
C’ GFP library on the background of CCT mutant

mitochondria36.99791.11025No
